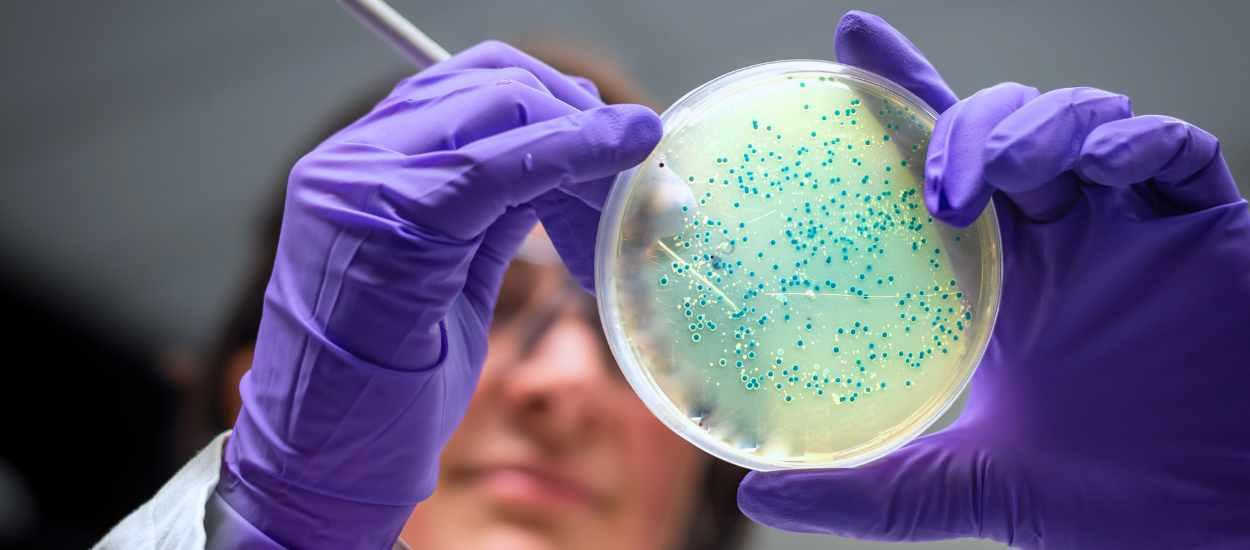

Ny EU-lag skärper kraven på listeriakontroll från 2026
Strängare krav hela vägen fram till utgångsdatum
Från och med den 1 juli 2026 ändras reglerna för listeria i livsmedel. Om det inte finns dokumentation som visar att listerianivån förblir under 100 cfu/g under hela hållbarhetstiden gäller kravet ”inte påvisbar i 25 gram” ända fram till utgångsdatumet. Reglerna följer EU-förordningen 2024/2895, som ändrar bilaga I till 2073/2005.
För mejerier innebär detta att listeria måste hållas under kontroll under hela perioden och inte bara vid leverans från mejeriet. Detta kräver ökad övervakning och dokumenterade åtgärder, särskilt för mjuka ostar och produktion baserad på råmjölk.
Lalcult Protect LC 1TM hjälper till att uppfylla kraven
Procudans partner Lallemand Speciality Cultures har en väldokumenterad lösning. Skyddskulturen Lalcult Protect LC 1TM hämmar effektivt tillväxten av listeria i ost och har redan implementerats på olika mejerier runt om i Europa.
Med de nya kraven har livsmedelsföretagen ansvaret ända fram till utgångsdatum även när produkterna finns hos konsumenten.
Felaktig förvaring kan ge listeria bättre tillväxtförhållanden, men här kan tillsats av skyddskulturen fungera som en extra säkerhet som minskar risken för att listeria utvecklas.
Så förbereder ni er
Om ni behöver rådgivning om den nya lagstiftningen och möjliga lösningar, kontakta en av våra kundansvariga:
- Carolina Carlotti på e-post cca@procudan.com eller telefon +46 761 143 335
- Joacim Traeholt på e-post jtr@procudan.com eller telefon +46 733 596 323
I samarbete med Lallemand Speciality Cultures hjälper vi er att utvärdera er nuvarande setup och hitta lösningar som skyddar mot listeria under hela hållbarhetstiden.